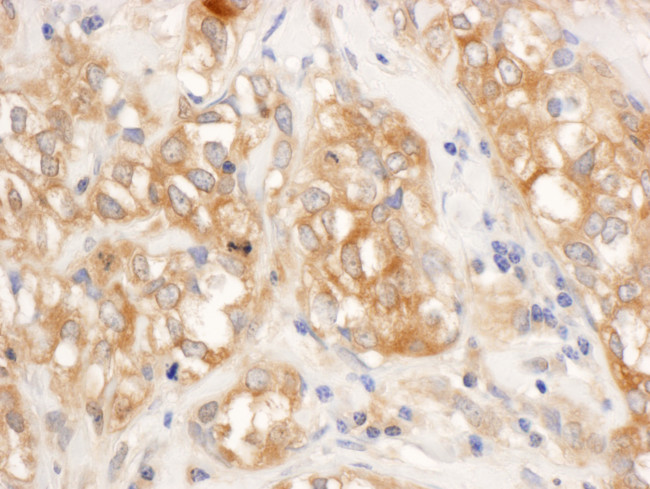
RelA Antibody in Immunohistochemistry (Paraffin) (IHC (P))

Search
Bethyl Laboratories
RelA Polyclonal Antibody
{{$productOrderCtrl.translations['antibody.pdp.commerceCard.promotion.promotions']}}
{{$productOrderCtrl.translations['antibody.pdp.commerceCard.promotion.viewpromo']}}
{{$productOrderCtrl.translations['antibody.pdp.commerceCard.promotion.promocode']}}: {{promo.promoCode}} {{promo.promoTitle}} {{promo.promoDescription}}. {{$productOrderCtrl.translations['antibody.pdp.commerceCard.promotion.learnmore']}}
产品信息
A301-824A
种属反应
宿主/亚型
分类
类型
抗原
偶联物
形式
浓度
规格
纯化类型
保存液
内含物
保存条件
运输条件
产品详细信息
The recommended shelf life for this product is 1 year from date of receipt.
Application Note: For IHC, epitope retrieval with citrate buffer pH 6.0 is recommended for FFPE tissue sections.
靶标信息
Nuclear factor kB p65 (NF-kB p65) is encoded by the RELA gene and is present on chromosome 11 in humans. NF-kB P65 is also known as RelA (v-rel avian reticuloendotheliosis viral oncogene homolog A) and belongs to the Rel family of proteins. It is one of the two subunits of NF-kB (Nuclear factor kappa-light-chain-enhancer of activated B cells) that heterodimerizes with the other subunits p50 or p52. However, binding of TNF alpha to its cognate receptor phosphorylates IKK which in turn phosphorylates I kB allowing proteasomal degradation of I kB. It specifically plays a key role in transcription of immunoglobulin k (kappa) gene in mature B-lymphoid cells.
仅用于科研。不用于诊断过程。未经明确授权不得转售。
篇参考文献 (0)
生物信息学
蛋白别名: avian reticuloendotheliosis viral (v-rel) oncogene homolog A; EBP-1; MGC131774; NF KB; nf-kappa-b p65; NF-kappa-B p65delta3; NF-kappa-B transcription factor p65; NF-kB p65; NFkappaB p65; nfkb rela; NFkB-p50; NFKB1; nuclear factor; nuclear factor kappa b; Nuclear factor NF-kappa-B p65 subunit; Nuclear factor of kappa light polypeptide gene enhancer in B-cells 3; p65 NF kappaB; p65 NF-kappa B; p65 NFkB; REL A; Transcription factor p65; unnamed protein product; v-rel avian reticuloendotheliosis viral oncogene homolog A
基因别名: AIF3BL3; CMCU; NFKB3; p65; RELA
UniProt ID: (Human) Q04206, (Mouse) Q04207
Entrez Gene ID: (Human) 5970, (Mouse) 19697